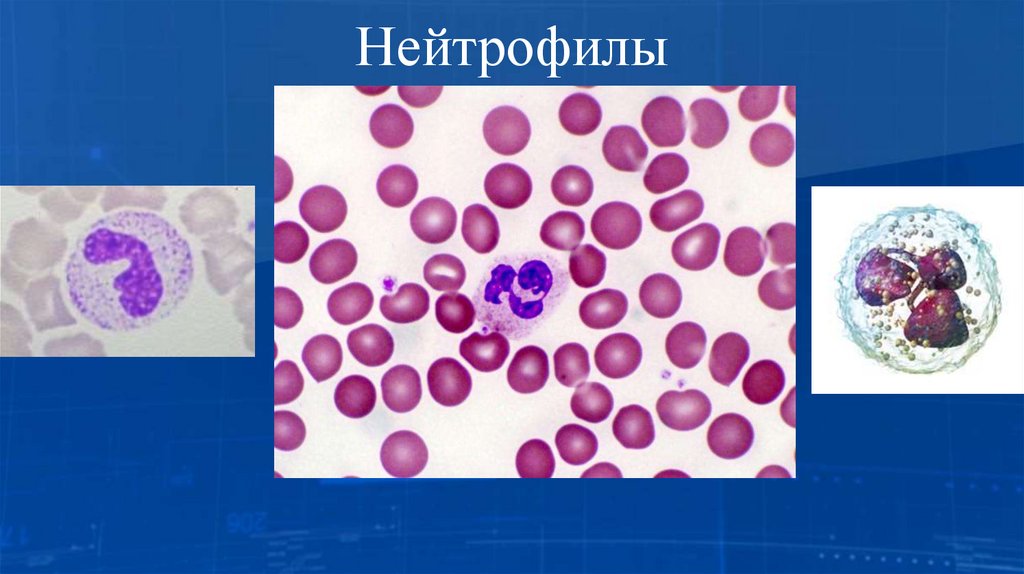
Нейтрофилы

Similar presentations:
Понятие об иммунитете. Условия выработки поствакцинального иммунитета. Характеристика течения вакцинального процесса
1.
Понятие об иммунитете. Условия выработкипоствакцинального иммунитета.
Характеристика течения нормального
вакцинального процесса.
Пименов А.С.
Врач-эпидемиолог.
г. Челябинск, 2025г.
2. Содержание
1.Ведение.
2.
Назначение иммунитета.
3.
Иммунная система.
4.
Классификация иммунитета.
5.
Органы иммунной системы.
6.
Клетки, участвующие в иммунном ответе.
7.
Уровни защиты.
8.
Иммунный ответ.
9.
Иммунобиологические лекарственные препараты.
10. Условия выработки поствакцинального иммунитета.
11. Характеристика течения нормального вакцинального процесса.
12. Выводы.
3. Введение
• Иммунитет – это способ защиты организма от антигеновэкзогенного (внешнего) и эндогенного (внутреннего)
происхождения, направленный на поддержание и сохранение
гомеостаза, структурной и функциональной целостности
организма, биологической индивидуальности каждого
организма и, как следствие, вида в целом.
4. Назначение иммунитета
• Простейшие защитные механизмы, имеющие своей цельюраспознавание и обезвреживание патогенов, существуют
даже у прокариот: например, ряд бактерий обладает
ферментными системами, которые препятствуют заражению
бактерии вирусом. Одноклеточные эукариотные организмы
применяют токсичные пептиды, чтобы предотвратить
проникновение бактерий и вирусов в свои клетки.
• По мере эволюции сложно организованных многоклеточных
организмов у них формируется многоуровневая иммунная
система,
важнейшим
звеном
которой
становятся
специализированные клетки, противостоящие вторжению
генетически чужеродных объектов.
5. Назначение иммунитета
• У таких организмов иммунный ответ происходит пристолкновении данного организма с самым различным
чужеродным в антигенном отношении материалом, включая
вирусы, бактерии и другие микроорганизмы, обладающие
иммуногенными свойствами молекулы (прежде всего белки,
а также полисахариды и даже некоторые простые вещества,
если последние образуют комплексы с белками-носителями
— гаптены), трансплантаты или мутационно изменённые
собственные клетки организма.
6. Назначение иммунитета
• Как отмечает В. Г. Галактионов, «иммунитет есть способзащиты организма от всех антигенно чужеродных веществ
как экзогенной, так и эндогенной природы; биологический
смысл подобной защиты — обеспечение генетической
целостности особей вида в течение их индивидуальной
жизни». Биологическим смыслом такой защиты является
обеспечение генетической целостности особей вида на
протяжении их индивидуальной жизни, так что иммунитет
выступает как фактор стабильности онтогенеза.
7. Назначение иммунитета
Характерные признаки иммунной системы:• способность отличать «своё» от «чужого»;
• формирование памяти после первичного контакта с
чужеродным антигенным материалом;
• клональная организация иммунокомпетентных клеток, при
которой отдельный клеточный клон способен, как правило,
реагировать лишь на одну из множества антигенных
детерминант.
8. Иммунная система
• Иммунная система — система биологических структур ипроцессов организма, обеспечивающая его защиту от
инфекций, токсинов и злокачественных клеток. Для
правильной работы иммунной системы необходимо, чтобы
она умела распознавать широкий спектр патогенов — от
вирусов до многоклеточных червей — и отличать их от
собственных здоровых тканей организма. У многих видов
имеются две подсистемы: врождённая иммунная система и
приобретённая (адаптивная) иммунная система. Обе
подсистемы используют как гуморальные механизмы, так и
клеточные механизмы.
9. Иммунная система
• К числу древнейших механизмов иммунной системыживотных относят фагоцитоз, систему комплемента и
антимикробные пептиды. Адаптивная иммунная система в
ходе эволюции появилась у челюстноротых позвоночных
животных. Один из важнейших механизмов адаптивной
иммунной системы — иммунологическая память, благодаря
которой организм развивает более сильный иммунный ответ
на патоген после первой встречи с ним. Основу вакцинации
составляет именно иммунологическая память.
10. Иммунная система
• Нарушения в работе иммунной системы приводят квозникновению аутоиммунных заболеваний, воспалительных
заболеваний и рака. Когда иммунная система функционирует
слабо, наблюдаются иммунодефицитные состояния, из-за
которых организм становится более уязвим для инфекций.
Иммунодефицит
может
быть
как
врождённым,
обусловленным генетическими отклонениями, так и
приобретённым, например, в результате ВИЧ-инфекции или
приёма препаратов-иммуносупрессоров.
11. Классификация иммунитета
• Иммунная система исторически описывается состоящей издвух частей — системы гуморального иммунитета и системы
клеточного иммунитета. В случае гуморального иммунитета
защитные функции выполняют молекулы, находящиеся в
плазме крови, а не клеточные элементы. В то время как в
случае клеточного иммунитета защитная функция связана
именно с клетками иммунной системы.
• Иммунитет также классифицируют на врождённый и
адаптивный.
12. Классификация иммунитета
• Врождённый(неспецифический,
наследственный[9])
иммунитет обусловлен способностью идентифицировать и
обезвреживать разнообразные патогены по наиболее
консервативным, общим для них признакам, дальности
эволюционного родства, до первой встречи с ними. В 2011
году была вручена Нобелевская премия в области медицины
и физиологии за изучение новых механизмов работы
врождённого иммунитета (Ральф Стайнман, Жюль Хоффман
и Брюс Бётлер). Осуществляется большей частью клетками
миелоидного ряда, не имеет строгой специфичности к
антигенам, не имеет клонального ответа, не обладает
памятью о первичном контакте с чужеродным агентом.
13. Классификация иммунитета
• Адаптивный (устар. приобретённый, специфический)иммунитет имеет способность распознавать и реагировать на
индивидуальные антигены, характеризуется клональным
ответом, в реакцию вовлекаются лимфоидные клетки,
имеется иммунологическая память, возможна аутоагрессия.
Классифицируют на активный и пассивный.
• Приобретённый активный иммунитет возникает после
перенесённого заболевания или после введения вакцины.
• Приобретённый пассивный иммунитет развивается при
введении в организм готовых антител в виде сыворотки или
передаче их новорождённому с молозивом матери или
внутриутробным способом.
14. Классификация иммунитета
Другая классификация разделяет иммунитет на естественныйи искусственный:
• Естественный иммунитет включает врождённый иммунитет
и
приобретённый
активный
(после
перенесённого
заболевания), а также пассивный иммунитет при передаче
антител ребёнку от матери.
• Искусственный иммунитет включает приобретённый
активный после вакцинации (введение вакцины или
анатоксина) и приобретённый пассивный (введение
сыворотки).
15. Органы иммунной системы
Выделяют центральные и периферические органы иммуннойсистемы. К центральным органам относят красный костный
мозг и тимус, а к периферическим — селезёнку,
лимфатические узлы, а также мукозальную иммунную систему
(МИС) представленной мукозо-ассоциированной лимфоидной
тканью (МАЛТ): бронхо-ассоциированной (БАЛТ), кишечноассоциированной (КАЛТ) (М-клетки, пейеровы бляшки),
назально-ассоциированной (НАЛТ) и др.
16. Органы иммунной системы
Красный костный мозг — центральный орган кроветворения ииммуногенеза. Содержит самоподдерживающуюся популяцию
стволовых клеток. Красный костный мозг находится в ячейках
губчатого вещества плоских костей и в эпифизах трубчатых
костей. Здесь происходит дифференцировка В-лимфоцитов из
предшественников. Содержит также Т-лимфоциты.
Тимус — центральный орган иммунной системы. В нём
происходит
дифференцировка
Т-лимфоцитов
из
предшественников, поступающих из красного костного мозга.
17. Органы иммунной системы
Лимфатические узлы — периферические органы иммуннойсистемы. Они располагаются по ходу лимфатических сосудов.
В каждом узле выделяют корковое и мозговое вещество. В
корковом веществе есть В-зависимые зоны и Т-зависимые
зоны. В мозговом есть только Т-зависимые зоны.
18. Органы иммунной системы
Селезёнка — паренхиматозный зональный орган. Являетсясамым крупным органом иммунной системы, кроме того,
выполняет депонирующую функцию по отношению к крови.
Селезёнка покрыта капсулой из плотной соединительной
ткани,
которая
содержит
гладкомышечные
клетки,
позволяющие ей при необходимости сокращаться. Паренхима
представлена двумя функционально различными зонами:
белой и красной пульпой. Белая пульпа составляет 20 %,
представлена лимфоидной тканью. Здесь имеются Взависимые и Т-зависимые зоны. И также здесь есть макрофаги.
Красная пульпа составляет 80 %.
19. Органы иммунной системы
Селезёнка выполняет следующие функции:• Депонирование зрелых форменных элементов крови.
• Контроль состояния и разрушения старых и повреждённых
эритроцитов и тромбоцитов.
• Фагоцитоз инородных частиц.
• Обеспечение дозревания лимфоидных клеток и превращение
моноцитов в макрофаги.
20. Клетки, участвующие в иммунном ответе
• T-лимфоциты – субпопуляция лимфоцитов, отвечающаяглавным образом за клеточный иммунный ответ. Включает в
себя субпопуляции Т-хелперов (дополнительно разделяются
на Th1, Th2, а также выделяют Treg, Th9, Th17, Th22,),
цитотоксических Т-лимфоцитов, NKT. Включает в себя
эффектор, регуляторы и долгоживущие клетки-памяти.
Функции разнообразны: как регуляторы и администраторы
иммунного
ответа
(Т-хелперы),
так
и
киллеры
(цитотоксические Т-лимфоциты).
21. Клетки, участвующие в иммунном ответе
• B-лимфоциты – субпопуляция лимфоцитов, синтезирующаяантитела и отвечающая за гуморальный иммунный ответ.
• Натуральные киллеры (NK-клетки) — субпопуляция
лимфоцитов, обладающая цитотоксичной активностью, то
есть они способны контактировать с клетками-мишенями,
секретировать токсичные для них белки, убивать их или
отправлять в апоптоз. Натуральные киллеры распознают
клетки, поражённые вирусами и опухолевые клетки.
22. Клетки, участвующие в иммунном ответе
• Нейтрофилы — это неделящиеся и короткоживущие клетки.Они составляют 65-70 % от гранулоцитов. Нейтрофилы
содержат огромное количество антибиотических белков,
которые содержатся в различных гранулах. К этим белкам
относятся лизоцим (мурамидаза), липопероксидаза и другие
антибиотические
белки.
Нейтрофилы
способны
самостоятельно мигрировать к месту нахождения антигена,
так как у них есть рецепторы хемотаксиса (двигательная
реакция на химическое вещество). Нейтрофилы способны
«прилипать» к эндотелию сосудов и далее мигрировать через
стенку к месту нахождения антигенов.
23. Нейтрофилы
24. Клетки, участвующие в иммунном ответе
• Эозинофилы составляют 2—5 % от гранулоцитов. Способныфагоцитировать микробы и уничтожать их. Но это не
является их главной функцией. Главным объектом
эозинофилов являются гельминты. Эозинофилы узнают
гельминтов и экзоцитируют в зону контакта вещества —
перфорины. Эти белки встраиваются в билипидный слой
клеток гельминта. В них образуются поры, внутрь клеток
устремляется вода, и гельминт погибает от осмотического
шока.
25. Клетки, участвующие в иммунном ответе
• Базофилы составляют 0,5-1 % от гранулоцитов. Существуютдве
формы
базофилов:
собственно
базофилы,
циркулирующие в крови, и тучные клетки, находящиеся в
ткани. Тучные клетки располагаются в различных тканях,
лёгких, слизистых и вдоль сосудов. Они способны
вырабатывать вещества, стимулирующие анафилаксию
(расширение сосудов, сокращение гладких мышц, сужение
бронхов). При этом происходит взаимодействие с
иммуноглобулином Е (IgE). Таким образом они участвуют в
аллергических реакциях. В частности, в реакциях
немедленного типа.
26. Клетки, участвующие в иммунном ответе
• Моноциты превращаются в макрофаги при переходе изкровеносной системы в ткани, существуют несколько видов
макрофагов в зависимости от типа ткани, в которой они
находятся, в том числе:
• Некоторые антигенпрезентирующие клетки, в первую
очередь дендритные клетки, роль которых — поглощение
микробов и «представление» их Т-лимфоцитам.
• Клетки Купфера — специализированные макрофаги печени,
являющиеся частью ретикулоэндотелиальной системы.
• Альвеолярные макрофаги — специализированные макрофаги
лёгких.
27. Клетки, участвующие в иммунном ответе
• Остеокласты—
костные
макрофаги,
гигантские
многоядерные клетки позвоночных животных, удаляющие
костную ткань посредством растворения минеральной
составляющей и разрушения коллагена.
• Микроглия — специализированный класс глиальных клеток
центральной
нервной
системы,
которые
являются
фагоцитами, уничтожающими инфекционные агенты и
разрушающими нервные клетки.
• Кишечные макрофаги и т. д.
28. Клетки, участвующие в иммунном ответе
• Функции их разнообразны и включают в себя фагоцитоз,взаимодействие с адаптивной иммунной системой и
инициацию и поддержание иммунного ответа, поддержание и
регулирование процесса воспаления, взаимодействие с
нейтрофилами и привлечение их в очаг воспаления,
выделение цитокинов, регуляция репарации, регуляция
процессов свертывания крови и проницаемости капилляров в
очаге воспаления, синтез компонентов системы комплемента.
29. Клетки, участвующие в иммунном ответе
• Макрофаги, нейтрофилы, эозинофилы, базофилы инатуральные
киллеры
обеспечивают
прохождение
врождённого иммунного ответа, который является
неспецифичным (в патологии неспецифичный ответ на
альтерацию называют воспалением, воспаление является
неспецифической фазой последующих специфических
иммунных).
30. Клетки, участвующие в иммунном ответе
31.
32. Уровни защиты
• Иммунная система обеспечивает защиту организма отинфекций на нескольких уровнях с повышающейся
специфичностью. Организм имеет физические барьеры,
мешающие проникновению в него вирусов и бактерий. Если
патогену удаётся их преодолеть, то он сталкивается со
врождённой иммунной системой, которая обеспечивает
быстрый, но неспецифический ответ. Врождённая иммунная
система имеется у растений и животных. У позвоночных,
если патоген преодолевает врождённый иммунный ответ, он
сталкивается со следующим рубежом защиты — адаптивной
иммунной системой.
33. Уровни защиты
• Адаптивная иммунная система обеспечивает специфическийиммунный ответ, направленный против конкретного
патогена. После того, как патоген был уничтожен, адаптивная
иммунная система «запоминает» его с помощью
иммунологической памяти, благодаря которой при повторной
встрече с патогеном организм сможет быстро развить
специфический иммунный ответ против него. В таблице
ниже перечислены основные компоненты врождённой и
адаптивной иммунной систем.
34. Уровни защиты
Врождённая иммунная системаАдаптивная иммунная система
Ответ неспецифичен
Специфический ответ
Обеспечивает немедленный иммунный
ответ умеренной силы
Обеспечивает отложенный сильный
иммунный ответ
Имеет клеточную и гуморальную
составляющую
Имеет клеточную и гуморальную
составляющую
Нет иммунологической памяти
После первого столкновения с патогеном
появляется иммунологическая память
Есть практически у всех форм жизни
Есть только у челюстноротых позвоночных
животных
35. Уровни защиты
• Кожа, роговица и слизистая оболочка дыхательных путей,желудочно-кишечного и урогенитального трактов образуют
физический барьер, являющийся первой линией защиты
человеческого тела. Некоторые из этих барьеров обладают
активными иммунными функциями:
• Внешний, ороговевший эпидермис: Кератиноциты кожи
секретируют антимикробные пептиды (дефензины), а
сальные и потовые железы секретируют субстанции,
подавляющие рост микробов (например, молочная кислота,
жирные кислоты).
36. Уровни защиты
• Также в коже присутствуют многие другие иммунные клетки(например, тучные клетки, интраэпителиальные лимфоциты,
антиген-презентирующие клетки Лангерганса).
• Роговица: нейтрофилы достигают роговицы через сосуды
лимба и уничтожают микробы фагоцитозом.
• Слизистая оболочка дыхательных путей, желудочнокишечного и мочеполового трактов: слизистая оболочка
содержит антимикробные вещества, такие как лизоцим,
лактоферины и секреторный иммуноглобулин (Ig) А (SIgA).
37. Уровни защиты
• Врожденный иммунитет• Чтобы быть полностью эффективным, врожденному
(естественному) иммунитету не требуется предварительного
контакта с антигеном (т.е., иммунологической памяти).
Таким образом, он немедленно отвечает на чужеродный
агент. Врожденный иммунитет распознает, главным образом,
широко распространенные молекулярные конфигурации, а не
антиген, специфичный для одного организма или клетки.
38. Уровни защиты
Компонентами врожденного иммунитета являются:• Фагоцитарные клетки (например, нейтрофилы, моноциты,
макрофаги)
• Полиморфно-ядерные лейкоциты
• Врожденные лимфоидные клетки (например, натуральные
клетки-киллеры [ЕКК])
39. Уровни защиты
Приобретенному же (адаптивному) иммунитету, для того,чтобы
быть
полностью
эффективным,
требуется
предварительный контакт с антигеном, потому что ему
необходимо время для развития реакции после первичной
встречи с новым возбудителем заболевания. Далее следует
быстрый ответ. Система запоминает предшествующие
контакты и является АГ-специфичной.
40. Уровни защиты
Компонентами приобретенного иммунитета являются:В-клетки и Т-клетки
Приобретенный иммунитет включает:
Гуморальный иммунитет: обеспечивается В-клеточным
ответом (В-клетки превращаются в плазматические клетки,
которые секретируют растворимые антиген-специфические
антитела).
Клеточный иммунитет: обеспечивается рядом Т-клеточных
реакций. B-клетки и Т-клетки работают вместе, уничтожая
инородные элементы. Тканевые антигенпрезентирующие
клетки необходимы для экспонирования АГ большинству
типов Т-клеток.
41. Иммунный ответ
• Успешная иммунная защита требует активации, регуляции иреализации иммунного ответа.
• Клетки иммунной системы активируются чужеродным
антигеном (АГ), который распознается клеточными
рецепторами. Эти рецепторы поверхности клетки могут быть
• Низкоспецифичными (например, рецепторы распознавания
образов, такие как Toll-подобный рецептор, рецептор
маннозы, фагоцитарный рецептор на дендритных и других
клетках)
• Высокоспецифичными (антитела экспрессируются на Вклетках или Т-клеточных рецепторах, экспрессируемых на Тклетках)
42. Иммунный ответ
• Будучи один раз распознанными, антиген, комплексыантиген-антитело
или
комплемент-микроорганизм
подвергаются
интернализации.
Большинство
микроорганизмов после фагоцитирования погибают.
• Пока АГ подвергается быстрому фагоцитозу и полностью
разрушается (нечастый случай), работает приобретенный
иммунный ответ посредством распознавания антигена
высокоспецифичными рецепторами на поверхности В- и Тклеток.
43. Иммунный ответ
• Иммунныйответ
должен
регулироваться
для
предотвращения подавляющего повреждения хозяина
(например, при анафилаксии, цитокиновой недостаточности,
синдроме
высвобождения
цитокинов
и
массивной
деструкции тканей). Регуляторные Т-клетки способствуют
контролю иммунного ответа посредством секреции
цитокинов-иммуносупрессоров, таких как ИЛ-10 и
трансформирующий фактор роста-бета или же посредством
механизма клеточного контакта. Данные регуляторные
клетки предотвращают возникновение аутоиммунного
ответа, и по-видимому, способствуют реализации ответов на
несобственные (чужеродные) АГ.
44. Иммунный ответ
• Завершение иммунного ответа происходит тогда, когда АГотделен или удален из организма. Без антигенной
стимуляции
прекращается
секреция
цитокинов
и
активированные цитотоксические клетки подвергаются
апоптозу. Апоптоз маркирует клетку для незамедлительно
следующего
фагоцитоза,
препятствующего
потере
клеточного содержимого и развитию воспаления. Т-клетки и
В-клетки, дифференцированные в клетки памяти, избегают
данной участи.
45. Иммунобиологические лекарственные препараты
• Иммунобиологические препараты (ИМП) – это препараты,которые оказывают влияние на иммунную систему или
действие которых основано на иммунологических реакциях.
• Эти препараты применяют для профилактики, лечения и
диагностики
инфекционных
заболеваний
и
тех
неинфекционных заболеваний, в развитии которых участвует
иммунная система.
46. Иммунобиологические лекарственные препараты
К иммунобиологическим препаратам относят:1. Вакцины и другие (анатоксины, фаги, эубиотики) лечебные
и профилактические препараты из живых микробов или
микробных продуктов.
2. Иммунные сывороточные препараты.
3. Иммуномодуляторы.
4. Диагностические препараты, в том числе аллергены.
• ИМП применяют для активации, подавления или
нормализации деятельности иммунной системы.
47. Иммунобиологические лекарственные препараты
К иммунобиологическим препаратам относят:1. Вакцины и другие (анатоксины, фаги, эубиотики) лечебные
и профилактические препараты из живых микробов или
микробных продуктов.
2. Иммунные сывороточные препараты.
3. Иммуномодуляторы.
4. Диагностические препараты, в том числе аллергены.
• ИМП применяют для активации, подавления или
нормализации деятельности иммунной системы.
48. Вакцины
Вакцины – это препараты для создания активногоискусственно
приобретенного
иммунитета.
Вакцины
применяют для профилактики, реже – для лечения
заболеваний. Действующее начало вакцин – специфический
антиген.
Классификация вакцин:
1. Живые вакцины:
- аттенуированные (ослабленные);
- дивергентные;
- векторные рекомбинантные.
49. Вакцины
Классификация вакцин:2. Неживые вакцины:
- молекулярные;
- корпускулярные: а) цельноклеточные и цельновирионные;
б) субклеточные и субвирионные; в) синтетические,
полусинтетические.
3. Ассоциированные вакцины.
50. Вакцины
Живые аттенуированные вакцины – препараты из ослабленныхмикробов, потерявших вирулентность, но сохранивших
иммуногенность. Ослабленные микробы – это вакцинные
штаммы.
Способы получения вакцинных штаммов:
а) метод отбора мутантов с ослабленной вирулентностью;
б)
метод
направленного
(искусственного)
снижения
вирулентности
(выращивание
на
неблагоприятных
питательных
средах,
длительное
пассирование
(последовательное
заражение)
через
организм
маловоспримчивых лабораторных животных);
51. Вакцины
Способы получения вакцинных штаммов:в) метод генной инженерии (инактивация гена, который
отвечает за образование факторов вирулентности патогенных
микробов).
Вакцинные штаммы микробов сохраняют способность
размножаться в месте введения и распространяться по
организму. В результате этого возникает вакцинная инфекция
(заболевание протекает в легкой форме). Вакцинная инфекция
всегда приводит к формированию иммунитета к патогенным
микробам данного вида, к которым относится вакцинный
штамм.
52. Вакцины
• Дивергентные вакцины – препараты из живых микробов, неболезнетворных для человека, но сходных по антигенным
свойствам с болезнетворными микробами. Например, для
прививки против оспы человека используют вирус оспы
коров.
• Векторные рекомбинантные вакцины получают методом
генной инженерии. Для этого в геном вакцинного штамма
встраивают ген (вектор), контролирующий образование
антигенов другого возбудителя (чужеродного антигена).
Например, в штамм вируса оспенной вакцины встраивают
антиген вируса гепатита В(HBs – антиген). Такая векторная
вакцина создает иммунитет и против оспы и против гепатита
В.
53. Вакцины
Преимущества живых вакцин:1) создание прочного (напряженного) и длительного
иммунитета (5-7 лет);
2) прививки делают однократно более простыми способами
(перорально, интраназально, накожно, подкожно);
3) менее реактогенны, т.к. не содержат консервантов и
адъювантов.
54. Вакцины
Недостатки живых вакцин:1) трудоемкость получения вакцинных штаммов;
2) малый срок хранения (1 – 2 года);
3) хранение и транспортировка при пониженной температуре
(+4С - +8С).
55. Вакцины
Для обеспечения безопасности живых вакцин необходимопроводить постоянный контроль реверсии вирулентности
возбудителя, строго соблюдать требования, обеспечивающие
сохранность и активность вакцинных микробов.
• Примеры живых вакцин:
1) бактериальные вакцины – туберкулезная (БЦЖ), чумная,
туляремийная, сибиреязвенная, бруцеллезная, против Кулихорадки;
2) вирусные вакцины – полиомиелитная, коревая, гриппозная,
паротитная, против желтой лихорадки.
56. Вакцины
Характеристика неживых вакцин.Корпускулярные вакцины – препараты из инактивированных
культур патогенных (высоко вирулентных) или вакцинных
штаммов бактерий и вирусов. Способы инактивирования: 1)
физические: температура, УФ-лучи, ионизирующее излучение;
2) химические – формалин, спирт, ацетон, -пропиолактон.
Корпускулярные вакцины из целых бактерий называют
цельноклеточными, а из целых (неразрушенных) вирусов –
цельновирионными.
57. Вакцины
Преимущества цельноклеточных и цельновирионных вакцин:1) простота получения;
2) большая устойчивость при хранении и более длительный
срок хранения.
Недостатки цельноклеточных и цельновирионных вакцин:
1) менее прочный и продолжительный иммунитет;
2) необходимость 2-х и 3-х-кратных прививок парентеральным
путем (подкожно, внутримышечно), иногда перорально;
3) реактогенность – боль, чувство жжения на месте введения,
повышение температуры, судорожный синдром и т.д.
58. Вакцины
Примеры вакцин: против гриппа, коклюша, холеры, гепатитаА, герпеса, вирусного энцефалита и др. Они используются для
профилактики соответствующих заболеваний. Некоторые
вакцины
используют
для
лечения
(вакцинотерапии)
хронических инфекционных заболеваний – бруцеллеза,
хронической дизентерии, хронической гонореи, хронических
стафилококковых инфекций. Для лечебных целей используют
и аутовакцины – препараты из убитых бактерий, выделенных
из организма больного.
59. Вакцины
Корпускулярные вакцины из разрушенных бактерий и вирусовназываются субклеточными и субвирионными. Такие вакцины
содержат антигенные комплексы, выделенные из бактерий и
вирусов после их разрушения.
Раньше эти вакцины назывались химическими. Однако этот
термин более применим к вакцинам, полученным методам
химического синтеза.
Получение субклеточных и субвирионных вакцин более
сложное, чем цельноклеточных и цельновирионных
(например, ферментативное переваривание с последующим
осаждением антигенов этиловым спиртом), но они содержат
меньше баластных веществ.
60. Вакцины
Преимущества субклеточных и субвирионных вакцин:1) содержат только иммунологически активные части клеток –
антигены без других компонентов;
2) менее реактогены;
3) более стабильны и лучше подвергаются стандартизации и
более точной дозировке;
4) можно вводить в больших дозах и в виде ассоциированных
препаратов.
Недостатки: 1) слабая иммуногенность;
2) малые размеры, что приводит к быстрому выведению и к
краткому антигенному раздражению.
61. Вакцины
Для устранения недостатков к таким вакцинам добавляютадъванты. Адъванты усиливают иммуногеность вакцин. Они
укрупняют антигенные частицы, создают в месте введения
"депо", из которого антигены медленно высвобождаются, что
удлиняет время их воздействия на иммунную систему. В
качестве адъювантов используют минеральные коллоиды(
фосфат алюминия, фосфат кальция, гидрат окиси алюминия,
алюмо-калиевые
квасцы),
полимерные
вещества
(липополисахариды, синтетические полимеры), растительные
вещества (сапонины) и др. Вакцины с адъювантами
называются
адъювантными,
сорбированными,
адсорбированными или депонированными вакцинами.
62. Вакцины
Молекулярные вакцины – это специфические антигены вмолекулярной форме. Они могут быть получены путем
биосинтеза, химического синтеза и генной инженерии.
Метод биосинтеза заключается в том, что из микроба или из
культуральной жидкости выделяют протективный антиген в
молекулярной форме. Например, возбудители дифтерии,
ботулизма, столбняка при росте синтезируют и выделяют в
культуральную жидкость молекулы экзотоксинов. После
обработки формалином экзотоксины теряют свои токсические
свойства, но сохраняют иммуногенность.Таким образом, к
типичным молекулярным вакцинам, которые получают путем
биосинтеза, относятся анатоксины.
63. Вакцины
Ассоциированные вакцины состоят из вакцин разного типа ивырабатывают иммунитет к нескольким заболеваниям. Они
еще называются комплексными или поливалентными.
Они могут включать однородные антигены (например,
анатоксины) и антигены различной природы (например,
корпускулярные и молекулярные антигены, убитых и живых
микробов). Антигены в вакцинах содержатся в дозировках, не
создающих взаимной конкуренции, чтобы иммунитет
вырабатывался ко всем антигенам.
Пример ассоциированных вакцин: АКДС из столбнячного и
дифтерийного анатоксина и коклюшной корпускулярной
вакцины;
64. Сыворотки и иммуноглобулины.
• Сывороточные препараты содержат антитела, специфическисвязывающие и нейтрализующие определенные бактерии,
вирусы, токсины.
• Сыворотки
используют
для
лечения,
экстренной
профилактики и диагностики инфекционных заболеваний.
Различают
лечебно-профилактические
и
диагностические сыворотки.
• Лечебно-профилактические
сыворотки
получают
из крови гипериммунизированных животных (лошадей) и из
крови людей (донорской, плацентарной, абортивной),
переболевших или иммунизированных. Диагностические
сыворотки получают из крови иммунизированных кроликов.
65. Сыворотки и иммуноглобулины.
• Лечебно-профилактические сыворотки применяют длясоздания
пассивного
искусственно
приобретенного
иммунитета и делят на противовирусные, антибактериальные
и антитоксические. К диагностическим сывороткам
относятся
агглютинирующие,
преципитирующие,
гемолитические,
антивирусные
и
антитоксические
сыворотки. Преимущество сывороток перед вакцинами в том,
что они сразу же после введения создают иммунитет (12 – 24
час). Недостаток– непродолжительный иммунитет, т.к.
антитела - чужеродные белки, которые быстро (через 1 – 2
недели) выводятся из организма.
66. Сыворотки и иммуноглобулины.
• Иммуноглобулины, как и иммунныесыворотки бывают гомологичными и
гетерологичными. Гомологичные получают из крови
людей, гетерологичные – из крови
животных. Иммуноглобулины из крови человека бывают 2-х
видов:
• 1) противокоревой (нормальный) иммуноглобулин –
получают из донорской, плацентарной или абортивной крови
здоровых людей, которая содержит антитела против вируса
кори, вирусов гриппа, гепатита, полиомиелита, против
коклюша и некоторых других бактериальных и вирусных
инфекций;
67. Сыворотки и иммуноглобулины.
• 2) иммуноглобулины направленного действия – получают изкрови переболевших людей и добровольцев, которых
иммунизируют против определенной инфекции; они
содержат повышенные концентрации специфических антител
и
применяются
с
лечебной
целью;
получают
иммуноглобулины направленного действия против гриппа,
бешенства, оспы, клещевого энцефалита, столбняка и
стафилококковых инфекций.
68. Иммуномодуляторы
• Иммуномодуляторы – препараты, которые стимулируют,ингибируют или регулируют иммунные реакции. Они
воздействуют на активность иммунокомпетентных
клеток, процессы образования иммунных факторов. К
ним
относятся
интерферон,
интерлейкины,
миелопептиды, вещества тимуса, а также химические
вещества: декарис, циклоспорин А; препараты
микробного происхождения: продигиозан, пирогенал,
мурамилпептид. Иммуномодуляторы назначают при
опухолях, первичных и вторичных иммунодефицитах,
аутоиммунных заболеваниях.
69. Условия выработки поствакцинального иммунитета
• На развитие поствакцинального иммунитета влияютследующие факторы:
• факторы, связанные с самой вакциной
• факторы, зависящие от организма:
• состояние индивидуальной иммунной реактивности
• возраст
• наличие иммунодефицита
70. Условия выработки поствакцинального иммунитета
• На развитие поствакцинального иммунитетаследующие факторы:
• состояние организма в целом
• генетическая предрасположенность
• факторы, связанные с внешней средой:
• качество питания человека
• условия труда и быта
• климат
• физико-химические факторы среды
влияют
71. Характеристика течения нормального вакцинального процесса.
• Критерий эффективности вакцинации - выработкаадекватного иммунного ответа на вакцину при отсутствии
сильных прививочных реакций и поствакцинальных
осложнений (ПВО).
• Выделяют три фазы формирования поствакцинального
ответа: латентную, фазу роста и фазу снижения иммунитета.
Такая динамика изменений в иммунной системе
универсальна для формирования как гуморального, так и
клеточного иммунитета.
72. Характеристика течения нормального вакцинального процесса.
• Латентная фаза - интервал между введением антигена ипоявлением антител, цитотоксических клеток и эффекторов
гиперчувствительности замедленного типа. Длительность
этой фазы - несколько суток.
• Фаза роста - накопление антител и иммунокомпетентных
клеток в крови; её продолжительность для разных антигенов
составляет от 4 сут до 4 нед.
73. Характеристика течения нормального вакцинального процесса.
• Фаза снижения иммунитета происходит сначала быстро, азатем медленно (в течение нескольких лет или десятилетий).
Титры антител классов IgM и IgA падают быстрее, чем
класса IgG. Чем быстрее происходит ослабление иммунитета,
тем чаще необходимо вводить бустерные дозы вакцины для
поддержания напряжённого иммунитета.
74. Характеристика течения нормального вакцинального процесса.
• При первичном иммунном ответе вначале происходит синтезантител класса IgM. Они обладают высоким аффинитетом и
превосходят антитела других классов по активности в
реакциях агглютинации и лизиса микроорганизмов. В
последующем происходит переключение изотипа антител с
IgM на IgG.
75. Характеристика течения нормального вакцинального процесса.
• Вторичный иммунный ответ основан на быстром иинтенсивном образовании IgG антител. Повторное введение
вакцины - основа для достижения длительного и
напряжённого иммунитета против большинства патогенов.
Интервал между вакцинациями должен быть не меньше 1
мес; в противном случае антитела, сохранившиеся после
предыдущего введения вакцины, будут инактивировать
вводимый антиген и ослаблять вторичный ответ.
76. Заключение
• Вакцинация – это простой, безопасный и эффективныйспособ защиты от болезней до того, как человек вступит в
контакт с их возбудителями. Вакцинация задействует
естественные защитные механизмы организма для
формирования устойчивости к ряду инфекционных
заболеваний и делает вашу иммунную систему сильнее.
77. Заключение
• Как и болезни, вакцины тренируют иммунную системувыработке специфических антител. Однако вакцины
содержат только убитые или ослабленные формы
возбудителей той или иной болезни – вирусов или бактерий,
– которые не приводят к заболеванию и не создают риска
связанных с ним осложнений.
• Большинство вакцин применяются в форме инъекций, хотя
есть и пероральные вакцины (вводимые через рот), и
вакцины в форме назальных аэрозолей (вводимые через
нос).
78. Заключение
• Патогенетические механизмы выработки специфическогоиммунитета на бактериальные вакцины и анатоксины
связаны с преимущественной активацией Th1-лимфоцитов
ИЛ-2, включением в иммунный ответ В-лимфоцитов и
дифференцировкой их до плазматических клеток и Влимфоцитов памяти. При первом введении вакцины
происходит синтез низкоаффиннных антител IgM изотипа.
При повторных иммунизациях происходит переключение
синтеза на IgG антитела, которые составляют основу
противоинфекционной защиты.

medicine
medicine








